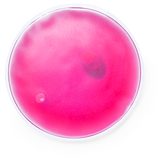
Taschenwärmer Idson

Das Produkt ist in der ausgewählten Währung nicht verfügbar.
Auf Lager
Auf Anfrage
Nachbestellt
Ausverkauft
Taschenwärmer Idson
Individuelle Taschenwärmer in Deinen Pantone-Farben – Perfekt für Deine Marke!
Wiederverwendbares und langlebiges Wärmepack in verschiedenen Farben - ideal für die Jackentaschen. Dieser Handwärmer bietet Ihnen somit eine nachhaltige Lösung für angenehme Wärme unterwegs.
Zur Aktivierung der Wärme, knicken Sie die kleine Metallmünze. Das Gel im Inneren des Wärmepacks verhärtet und erwärmt sich. Zur Wiederverwendung legen Sie das Pack für einige Sekunden in kochendes Wasser bis sich das Gel wieder in flüssigem Zustand befindet.
Du suchst nach einzigartigen Taschenwärmern für Deine Marke? Wir bieten Dir die Möglichkeit, ab einer Menge von 1000 Stück sowohl das Gel als auch die Aussenseite in Deinen eigenen Pantone-Farben herzustellen. Was uns besonders macht: Ab 1000 Stück bedrucken wir Deine Taschenwärmer auf der Innenseite der Folie – sowohl vorne als auch hinten. So garantieren wir Dir eine lange Haltbarkeit des Drucks, der auch bei häufigem Gebrauch nicht verblasst.
Zur Aktivierung der Wärme, knicken Sie die kleine Metallmünze. Das Gel im Inneren des Wärmepacks verhärtet und erwärmt sich. Zur Wiederverwendung legen Sie das Pack für einige Sekunden in kochendes Wasser bis sich das Gel wieder in flüssigem Zustand befindet.
Du suchst nach einzigartigen Taschenwärmern für Deine Marke? Wir bieten Dir die Möglichkeit, ab einer Menge von 1000 Stück sowohl das Gel als auch die Aussenseite in Deinen eigenen Pantone-Farben herzustellen. Was uns besonders macht: Ab 1000 Stück bedrucken wir Deine Taschenwärmer auf der Innenseite der Folie – sowohl vorne als auch hinten. So garantieren wir Dir eine lange Haltbarkeit des Drucks, der auch bei häufigem Gebrauch nicht verblasst.
Stelle noch heute Deine Anfrage – ganz einfach unterhalb des Buttons „In den Warenkorb“. Gemeinsam gestalten wir Deinen individuellen Taschenwärmer, der Deine Marke perfekt repräsentiert.
Möchtest Du mehr über das personalisierbare Firmengeschenk Taschenwärmer Idson erfahren? Unsere Experten helfen Dir gerne weiter!
- TAMPONDRUCK E
1-farbig - SIEBDRUCK D
1-farbig - TAMPONDRUCK F
1-farbig - SIEBDRUCK C
1-farbig - SIEBDRUCK E
1-farbig


Zentriert
Grösse: Breite: 4 cm und Höhe: 4 cm
Druckvorlage herunter ladenGrösse und Gewicht Artikel
Höhe: 10 mm, Durchmesser: 100 mm und Gewicht: 64 g
Verpackungsgrösse und Gewicht
Breite: 368 mm, Höhe: 135 mm, Länge: 520 mm, Verpackungseinheit: 150 Stk. und Gewicht: 11.5 kg
Palettengrösse und Gewicht
Einheiten: 9000 Stk., Pakete: 78 Stk. und Gewicht: 910 kg
Oops!
Es tut uns leid, es sieht aus das einige Produkte in ausgewählter Menge nicht verfügbar sind.
Von diesen Vorteilen profitierst du
Persönliche Beratung
Unsere erfahrenen Experten stehen dir jederzeit persönlich zur Seite und gehen auf deine individuellen Wünsche und Fragen ein. Denn exzellenter Service und persönliche Betreuung sind für uns selbstverständlich.
Profi Grafik-Service
Wir bieten professionelle Andruckmuster oder farbverbindliche Digitalproofs – für perfekte Ergebnisse ohne Kompromisse. Denn höchste Druckqualität ist kein Zufall, sondern unser Anspruch.
Warum wir?
We are not the best but better than the rest.Bei uns erhältst du ehrliche Beratung, kreative Ideen und einen ganzheitlichen Rundum-Service, der nicht nur verspricht, sondern überzeugt – mit Qualität, Leidenschaft und Zuverlässigkeit.
Individueller Druckservice
Durch modernste Drucktechnologien ermöglichen wir eine beeindruckende Vielfalt an Materialien und Verfahren. Wir fertigen personalisierte Geschenke und Werbeartikel wir auf höchstem Niveau.
Schnelle Lieferung
In nur 7 Tagen erhältst du deine personalisierten Express-Werbeartikel mit hochwertigem Logodruck – schnell, zuverlässig und termingerecht, damit dein Markenauftritt immer überzeugt.
Wir halten ein, was andere versprechen
Andere Werbemittel Anbieter
Verspätete Lieferungen
Viele Anbieter halten die versprochenen Lieferzeiten nicht ein, was zu Verzögerungen bei den Kundenprojekten führt.Support-Ticket-System
Anstelle eines direkten Ansprechpartners nutzen viele Firmen ein Support-Ticket-System, was die Kommunikation verlangsamt. Das bedeutet keine persönliche Betreuung und lange Wartezeiten auf Antworten.Mangelnde Produktqualität
Einige Anbieter bieten minderwertige Produkte an, die schneller verschleissen oder nicht den gewünschten Effekt erzielen. Die Qualität der Werbemittel spiegelt sich direkt in der Wahrnehmung deiner Marke wider.Begrenzte Produktauswahl
Eingeschränktes Sortiment und weniger Möglichkeiten zur Individualisierung. Kunden können nicht immer die spezifischen Anforderungen und Wünsche umsetzen.
Druckidee.ch
Zuverlässige Lieferzeiten
Wir garantieren dir die Einhaltung von Lieferzeiten, was entscheidend für die Planung ist. Du kannst sich darauf verlassen, dass deine Bestellungen pünktlich ankommen.Direkter Ansprechpartner
Du hast einen festen Ansprechpartner, der dir bei Fragen und Problemen direkt weiterhilft.Hochwertige Werbemittel
Wir bieten eine breite Palette an qualitativ hochwertigen Werbemitteln. Die Produkte sind langlebig und hinterlassen einen positiven Eindruck bei den Endkunden.Umfangreiche Auswahl und Flexibilität
Grosse Auswahl an individuell anpassbaren Produkten. Flexibilität bei der Gestaltung und Anpassung von Werbemitteln, um spezifischen Kundenbedürfnissen gerecht zu werden.